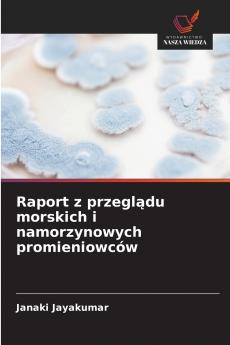
Raport z przeglądu morskich i namorzynowych promieniowców

Polish
Paperback
₹4364
(All inclusive*)
Delivery Options
Please enter pincode to check delivery time.
*COD & Shipping Charges may apply on certain items.
Review final details at checkout.
Looking to place a bulk order? SUBMIT DETAILS
About The Book
Description
Author
Promieniowce rosnące w środowiskach o wysokim zasoleniu stanowią ważne źródło związków biologicznie czynnych. Z obszarów tych wyizolowano wiele związków przeciwbakteryjnych przeciwgrzybiczych przeciwnowotworowych cytotoksycznych i fotoochronnych. Promieniowce morskie i namorzynowe mogą być źródłem leków o nowej chemii i obiecującym potencjale. Ponieważ obszary morskie i namorzynowe są ze sobą ściśle powiązane skonsolidowałem tutaj prace badawcze wykonane przez innych badaczy związanych tylko z tym obszarem. W niniejszej pracy skonsolidowano dostępne raporty dotyczące różnorodności aktywności antagonistycznej charakterystyki fizjologicznej i biochemicznej sekwencjonowania 16sRNA i analizy filogenetycznej związków bioaktywnych aktywności przeciwnowotworowej aktywności przeciwutleniającej aktywności larw komarów aktywności keratynazy oraz akumulacji i degradacji metali ciężkich. Zapewniam że niniejszy raport przeglądowy może pomóc w nadaniu nowego wymiaru badaniom nad namorzynami i morskimi promieniowcami. Dziękuję wszystkim badaczom którzy wykonali wspaniałą pracę w tej wyłaniającej się dziedzinie w celu lepszego dostarczania leków z morskich i namorzynowych promieniowców a także za ich wkład w nasze społeczeństwo.
Delivery Options
Please enter pincode to check delivery time.
*COD & Shipping Charges may apply on certain items.
Review final details at checkout.
Details
ISBN 13
9786208756239
Publication Date
-18-03-2025
Pages
-76
Weight
-116 grams
Dimensions
-152x229x4.62 mm